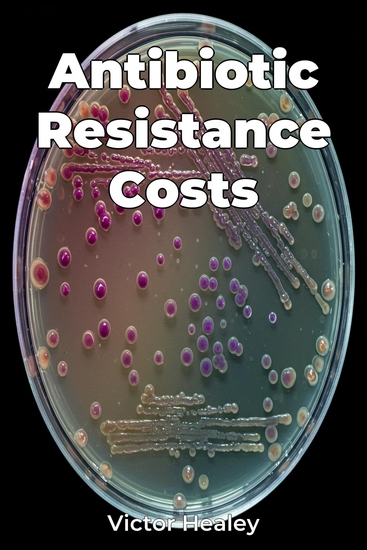

Antibiotic Resistance Costs
Victor Healey
Traducteur A AI
Maison d'édition: Publifye
Synopsis
Antibiotic Resistance Costs reveals the significant economic burden of antibiotic resistance, demonstrating that it is not only a public health issue but also a major economic threat. The book highlights the increased medical costs needed to treat resistant infections, the impact of lost productivity due to illness, and the long-term consequences for economic growth, especially in low- and middle-income countries. For example, treating infections that no longer respond to first-line antibiotics often requires more expensive and prolonged treatments, which strains healthcare systems. The book examines the history of antibiotic use and misuse, explaining how overuse in medicine and agriculture has fueled resistance. Structured to comprehensively analyze the economic dimensions, it begins with the science behind antibiotic resistance and its global prevalence. Progressing through chapters, it delves into treatment costs, productivity impacts, assesses long-term consequences, and concludes with policy recommendations. By integrating data from organizations like the World Health Organization and economic models, it quantifies the costs and projects the future economic impact, making it a valuable resource for policymakers and health economists.














